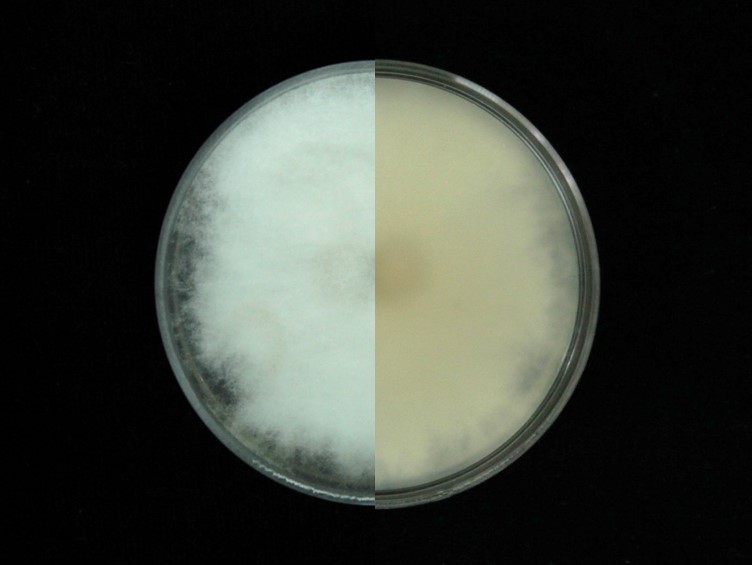

Description:
 Basidiocarps 3.0-10.0 mm wide, conchate, digitate, sessile or laterally stipitate,brown pilear surface with a whitish brilliant mycelial disc in the attachment point, and notorious orange-brown to brownish lamellae. Peilipellis 5.0-7.5 µm thick, septate, hyaline, clamp connection absent. Hymenium with gills 37.5 to 62.5 µm in length, tightly rolled.
Basidiocarps 3.0-10.0 mm wide, conchate, digitate, sessile or laterally stipitate,brown pilear surface with a whitish brilliant mycelial disc in the attachment point, and notorious orange-brown to brownish lamellae. Peilipellis 5.0-7.5 µm thick, septate, hyaline, clamp connection absent. Hymenium with gills 37.5 to 62.5 µm in length, tightly rolled.  Abhymenial hairs 3.7- 5.0 µm diam, septate, thick-walled, hyaline to pale brown, apexes slightly wavy or spiraled.
Abhymenial hairs 3.7- 5.0 µm diam, septate, thick-walled, hyaline to pale brown, apexes slightly wavy or spiraled.  Basidiospores 3.8-7.5 × 2.5 µm, ellipticals, yellow to brownish yellow, thin-walled, smooth.
Basidiospores 3.8-7.5 × 2.5 µm, ellipticals, yellow to brownish yellow, thin-walled, smooth.
Culture characteristics:
Spores germinated on PDA within 24 h. Colony was grown on PDA, white cottony, woolly of mycelium, reaching 5 cm in diam in 5-7 d at 25 °C, surface and reverse white to cream.
Colony was grown on PDA, white cottony, woolly of mycelium, reaching 5 cm in diam in 5-7 d at 25 °C, surface and reverse white to cream.
Reference:
Berkeley MJ (1851). Decades of fungi. Decades XXXI. Pyrenees and Pará fungi, collected by Mr. Spruce. Journal of Botany (Hooker) 3: 14–21.
DOI:Cerreño-ruiz SD, Lázaro AAA, García SVC. 2019. New record of Schizophyllum (Schizophyllaceae) from Mexico and the confirmation of its edibility in the humid tropics. Phytotaxa 413: 137–148.
DOI: https://doi.org/10.11646/phytotaxa.413.2.3Species |
Strain |
Compound |
Pubchem CID |
Biological activity |
Reference |
|---|
|
Strain |
|---|